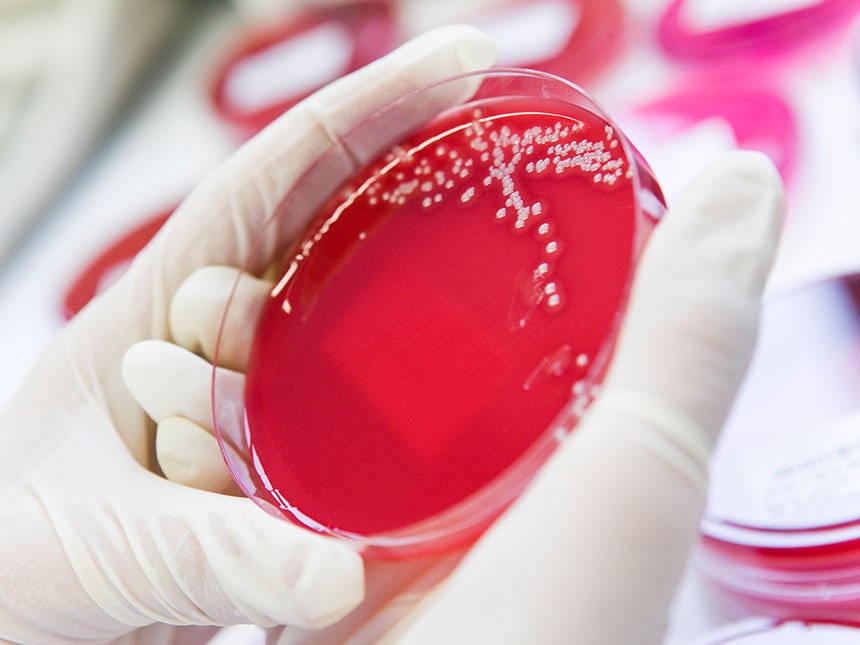

Abteilung für Laboratoriumsmedizin und Krankenhaus-hygiene
Fachabteilung für Labordiagnostik
Für eine gesicherte Diagnose von Erkrankungen sowie während deren Verlauf sind labormedizinische Verfahren nahezu in jedem Bereich der Medizin unerlässlich. Unsere Abteilung für Laboratoriumsmedizin und Krankenhaushygiene arbeitet im Hintergrund, aber jede Patientin:jeder Patient profitiert von unserer präzisen und umfassenden Diagnose- und Hygienearbeit im Robert Bosch Krankenhaus.
Einen Schwerpunkt der Abteilung bildet – neben den Routine-Blutuntersuchungen – die mikrobiologische Diagnostik. Damit können wir auch multiresistente Erreger wie MRSA und MRGN zuverlässig nachweisen und sämtliche Erreger auf ihre Resistenz gegenüber Antibiotika testen. Zudem führen wir Untersuchungen auf Viren durch, analysieren Blutgruppen und auftretende Antikörper.
Ein weiterer Abteilungsschwerpunkt ist die Krankenhaushygiene, die am Robert Bosch Krankenhaus seit vielen Jahren eine bedeutende Rolle spielt, um das Risiko von Infektionen umfassend und weitestgehend zu minimieren.
Die Abteilung verfügt über ein großes Blutdepot und erstellt rund um die Uhr an jedem Tag der Woche Befunde – auch in der mikrobiologischen Diagnostik.
Schwerpunkte
Abteilung für Laboratoriumsmedizin und Krankenhaushygiene
Klinische Chemie
Nachweis von Stoffwechselstörungen, Infektionen, Tumorwachstum etc.
Mikrobiologie
Krankheitserregern auf der Spur
Transfusionsmedizin
mit Blutdepot und Blutzellherstellung
Molekularbiologische Diagnostik
Genen und Erbsubstanzen auf der Spur
Forensische Alkohologie
mit ca. 12.000 Untersuchungen pro Jahr für große Teile Baden-Württembergs
Krankenhaushygiene
Infektionen vermeiden
Kontakt
zur Abteilung für Laboratoriumsmedizin und Krankenhaushygiene
Chefarzt
Prof. Dr. med.
Michael Torzewski, M. A.
Sekretariat
Daniela Tscherner-Meyer
Telefon 0711 8101-3500
Telefax 0711 8101-3618
daniela.tscherner@rbk.de
Sprechzeiten und Service für Einsender
24-Stunden-Bereitschaft
Telefon 0711 8101-3503
Lernen Sie das Team der Abteilung für Laboratoriumsmedizin und Krankenhaushygiene kennen.
Labor und Hygiene im Krankenhaus
Labor im Krankenhaus
Zur Diagnose von Erkrankungen sind labormedizinische Verfahren fast in jedem Bereich der Medizin unerlässlich geworden. Aber auch zum Verlauf von Krankheiten oder zur Kontrolle des Heilungsprozesses werden Methoden der Laboratoriumsmedizin angewendet.

Hygiene im Krankenhaus
Im Krankenhaus spielt Hygiene eine ganz besondere Rolle: Kranke Menschen sind meist geschwächt und dadurch besonders empfänglich für Infektionen. Wir sind deshalb für die Einhaltung hoher Hygienestandards verantwortlich.
Zusammenarbeit für bestmögliche Behandlung
Die leistungsfähige Abteilung für Laboratoriumsmedizin versorgt die 20 Fachabteilungen und über 15 medizinischen Zentren des Robert Bosch Krankenhauses und andere Einsender aus Krankenhaus (z. B. Kliniken Schmieder, Rems-Murr-Kliniken, Zentrum für Psychiatrie und Neurologie in Winnenden) rund um die Uhr mit Laboranalytik. Denn zur Diagnose von Erkrankungen sind labormedizinische Verfahren fast in jedem Bereich der Medizin unerlässlich geworden. Aber auch zum Verlauf von Krankheiten oder zur Kontrolle des Heilungsprozesses werden Methoden der Laboratoriumsmedizin angewendet.
≈ 4,5 Mio.
pro Jahr
≈ 12.000
forensischen Alkohologie für große
Teile Baden-Württembergs

Qualität und Patientensicherheit
in der Abteilung für Laboratoriumsmedizin und Krankenhaushygiene
Unser Anspruch ist es, jede Patientin und jeden Patienten von Beginn an mit höchster Qualität und so sicher wie möglich zu versorgen.

Forschung und klinische Studien
in der Abteilung für Laboratoriumsmedizin und Krankenhaushygiene
Das Robert Bosch Krankenhaus ist als Teil des Bosch Health Campus eng mit der Forschung verbunden. Neueste Erkenntnisse kommen Ihnen so direkt zu Gute. Auch ist die Teilnahme an einer klinischen Studie für viele Patient:innen eine Option – insbesondere wenn es keine guten Behandlungsmöglichkeiten gibt.
Karriere und Bildung

Ihre Karriere am RBK
Über 3.000 Mitarbeitende schätzen das Robert Bosch Krankenhaus als modernen Arbeitgeber. Werden auch Sie Teil unseres Teams.

Ihre berufliche Bildung
Das Irmgard Bosch Bildungszentrum bietet ein qualifiziertes Programm an Fort- und Weiterbildungen für Ihren beruflichen Erfolg.